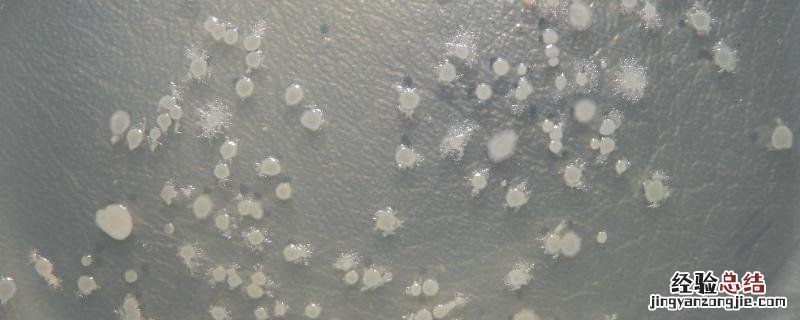

文章插图
【什么情况下使用芽孢菌调水,芽孢菌多少度能杀死】回答当池塘中有大量的悬浮物和底泥污染水源时 , 便可使用芽孢菌调水 。芽孢菌含有丰富的蛋白酶、脂肪酶和淀粉酶等,能分解池塘中的悬浮物和底泥,改善水质以及周围环境,维持水的生态环境平衡,还具有改善池塘水质、去除池塘中的氮与硫、分解淤泥以及使水体净化的作用 。
一、什么情况下使用芽孢菌调水
1、改善池塘水质
(1)芽孢杆菌通过酶的作用,能分解池塘的悬浮物和底泥,维持水生的生态环境平衡,将芽孢杆菌投入养殖池中,能降低水中的COD、BOD,改善水质和周围环境 。
(2)芽孢杆菌具有丰富的蛋白酶、脂肪酶、淀粉酶、纤维素酶、脱氢酶、脱羧酶和氧化酶等能强烈的分解碳系污染物,能分解蛋白质和复杂多糖,并对分解水溶性有机物也有重要的作用 。
(3)池塘中的悬浮物是由有机碎屑、细菌、藻类和矿物质等细微颗粒组成的胶粘状物,而底泥由有机碎屑、细菌和藻类组成 。
2、去除池塘中的氮与硫
(1)在池塘中用芽孢杆菌为主导菌的复合微生态制剂,含活菌数为109个/g , 首次用量为1.5-5.0mg/L,能增加溶解氧量,降低H2S、NO2-N等,改善养殖环境 。
(2)高密度集约化养殖严重污染塘的生态环境,过量的氮与硫引起池塘富营养化 , 在池塘中形成了对水产动物有害的H2S,影响动物生长,甚至死亡,而芽孢杆菌能够利用酶,强烈分解氮系和硫系污染物,净化养殖水体 。
3、分解淤泥
用芽孢杆菌为主的微生物复合制剂,能够分解淤泥,降解有机碳 。
4、水体净化
芽孢杆菌具有絮凝作用 , 可将水体中的有机碎屑粘连在一起,从而构成菌胶团 , 共同担负氧化分解的任务,把有机物结合成絮状,沉淀重金属离子以及P元素,达到水体净化的目的 。
二、芽孢菌多少度能杀死
1、一般温度121-126℃且持续30分钟,就能将芽孢菌杀死 。芽孢菌是细菌一科,能形成芽孢(内生孢子)的杆菌或者球菌,对外界有害因子抵抗力强,分布广 , 主要存在于土壤、水、空气以及动物肠道等地方 。
2、芽孢对热、放射线和化学物质等有很强的抵抗力,能除臭驱蝇 , 减少污染,控制细菌性疾病 , 减轻环境污染 。
3、芽孢菌与低浓度抗生素同时使用,但不能与杀菌剂、消毒剂、化学药品、农药等同时存放或使用 。
